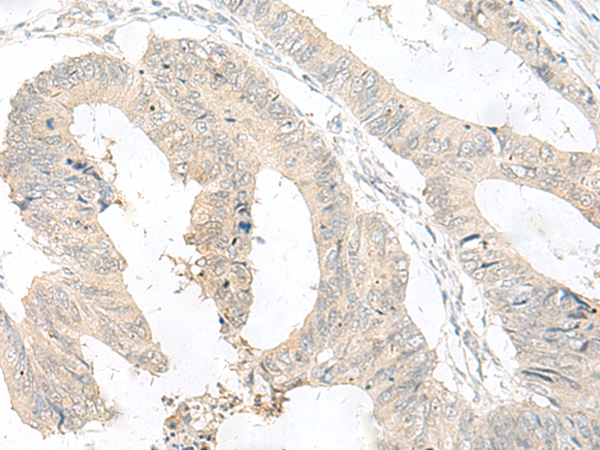

|
Background: |
This gene encodes a G protein-coupled receptor. Multiple alternatively spliced variants, encoding the same protein, have been identified. Orphan receptor. May play a role in brain function. |
|
Applications: |
ELISA, IHC |
|
Name of antibody: |
GPR63 |
|
Immunogen: |
Synthetic peptide of human GPR63 |
|
Full name: |
G protein-coupled receptor 63 |
|
Synonyms: |
PSP24B; PSP24(beta) |
|
SwissProt: |
Q9BZJ6 |
|
ELISA Recommended dilution: |
5000-10000 |
|
IHC positive control: |
Human cervical cancer and Human colorectal cancer |
|
IHC Recommend dilution: |
25-100 |
購(gòu)物車
幫助
021-54845833/15800441009
